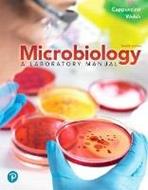

L’articolo è stato aggiunto alla lista dei desideri
IBS.it, l'altro eCommerce
Microbiology: A Laboratory Manual, Loose Leaf Edition
Cliccando su “Conferma” dichiari che il contenuto da te inserito è conforme alle Condizioni Generali d’Uso del Sito ed alle Linee Guida sui Contenuti Vietati. Puoi rileggere e modificare e successivamente confermare il tuo contenuto. Tra poche ore lo troverai online (in caso contrario verifica la conformità del contenuto alle policy del Sito).
Grazie per la tua recensione!
Tra poche ore la vedrai online (in caso contrario verifica la conformità del testo alle nostre linee guida). Dopo la pubblicazione per te +4 punti
Altre offerte vendute e spedite dai nostri venditori

Tutti i formati ed edizioni
Promo attive (1)
This loose-leaf, three-hole punched textbook that gives students the flexibility to take only what they need to class and add their own notes-all at an affordable price. For courses in Microbiology Lab and Nursing and Allied Health Microbiology Lab. Foundations in microbiology lab work with clinical and critical-thinking emphasis Microbiology: A Laboratory Manual, 12th Edition provides students with a solid underpinning of microbiology laboratory work while putting increased focus on clinical applications and critical-thinking skills, as required by today's instructors. The text is clear, comprehensive, and versatile, easily adapted to virtually any microbiology lab course and easily paired with any undergraduate microbiology text. The 12th Edition has been extensively updated to enhance the student experience and meet instructor requirements in a shifting learning environment. Updates and additions include clinical case studies, equipment and material checklists, new experiments, governing body guidelines, and more.
L'articolo è stato aggiunto al carrello
Le schede prodotto sono aggiornate in conformità al Regolamento UE 988/2023. Laddove ci fossero taluni dati non disponibili per ragioni indipendenti da IBS, vi informiamo che stiamo compiendo ogni ragionevole sforzo per inserirli. Vi invitiamo a controllare periodicamente il sito www.ibs.it per eventuali novità e aggiornamenti.
Per le vendite di prodotti da terze parti, ciascun venditore si assume la piena e diretta responsabilità per la commercializzazione del prodotto e per la sua conformità al Regolamento UE 988/2023, nonché alle normative nazionali ed europee vigenti.
Per informazioni sulla sicurezza dei prodotti, contattare productsafetyibs@feltrinelli.it
L’articolo è stato aggiunto alla lista dei desideri

